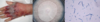
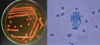

Infecciones Micoticas Flashcards
(80 cards)
Tipo de transmicion de tiña ungueal
Contacto directo o fomites
Cuanto tiempo pueden sobrevivir las artrosporas de los dermstofitos
12 meses
A que se puede asociar la tiña crural
Tiña de los pies
Genero de Fusarium mas cmoun
Fusarium solani 50%
Factores predisponentes para infeccion por Fusarium
Nuetropenia y linfopenia (trastornos hematologicos)
Se puede utilizar LASER CO2 para tratamiento de onicomicosis con Fusarium
Verdadero
Nuevo nombre de Scedosporium apiospermum
Scedosporium boydii
Presentacion mas comun de Scopulariopsis en infecciones cutaneas
Onicomicosis
Forma sexual de Scopulariopsis
Microascus
Que agente causal es y cuales son los hallazgos en cultivo y examen directo

Geotricosis
Colonia blanca vellosa humeda
Hifas tabicadas con multiples artroconidios
Prueba bioquimica que confirma el diagnostico de Geotrichum candidum
GLucosa
Que pruebas especiales pueden confirmar la presencia de Geotrichum capitatum
Resisente a cicloheximida
Crecimiento a 40 grados
Descripcion de cultivo y de imagen hace sugestivo el diagnostico de:

Aspergilus nidulans
Colonias polvorosas, amarillentas con pequeño halo blanco(micelial)
Septos hialinos con conidios que nacen de fialides angulo de 140° grados
Celulas redondas que se llaman celulas de Hülle(celulas de avellana)

Diagnostico que se obtiene mediante cultivo e imagen de examen directo

Aspergilus niger
Colonia con conidios negros
Cabezas aspergilares redondas negras angulo de 360°
Cual es el medio Biggy Nickerson
Bisulfito de sodio
que cuando se siembra de candida (solo crece candida sp)
En el medio de cromagar que color pinta la especie candida albicans
Verde
En medio cromagar que color pinta la candida tropicalis
Azul
En que consiste la prueba de tubo germinal, da como resultado…
Tubo germinal que se desarrolla en Candida albicans

Con este cultivo y examen directo se llega al diagnostico de:

Aspergilus flavus
Diagnostico que se llega mediante este cultivo y examen directo:

Aspergilus flavus
Colonia verde aterciopelada
Conidioforos largos
Fialides en 360° con dos series de fialides
Factores de patogenicidad de cryptococos
Transformacion de fenol oxidasa que transforma en pigementos melanicos(color negro)
Capsula
Prueba bioqumica para cryptococo que cambia el medio a color rosa
Ureasa

Diagnostico mediante hallazgo clinico y de cultivo

Mucormicosis por Cuningamella bertholatiae
Vesiculas con esterigmatas en forma de flor
Esporangiosporas
Diagnostico de cultivo

Mucor sp
Hifas cenociticas ramificadas
que encapsulan a los esporangioesporas